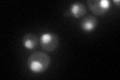
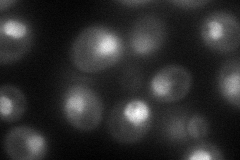
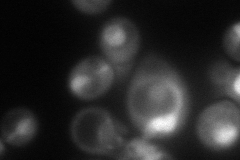
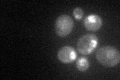

View description
Essential, non-ATPase regulatory subunit of the 26S proteasome lid required for the assembly and activity of the 26S proteasome; the human homolog (S9 protein) partially rescues Rpn6p depletion
Localization:
Intensity:
Fold change:
Significance:
-
C’ GFP library in SD
nucleus87.04 -
N' NOP1pr-GFP in SD
nucleus84.889 -
N' TEF2pr-mCherry in SD
nucleus,nucleolus105.344 -
N' NATIVEpr-GFP in SD

missing0 -
N' TEF2pr-VC and Cyto-VN in SD

#N/A0 -
C’ GFP library in SD+DTT

nucleus81.850.94No -
C’ GFP library in SD+H2O2

nucleus81.230.93No -
C’ GFP library in Starvation Media
nucleus66.980.76No -
C’ GFP library on the background of Pup2-DaMP

nucleus -
C’ GFP library on the background of CCT mutant

nucleus110.5831.27039No
